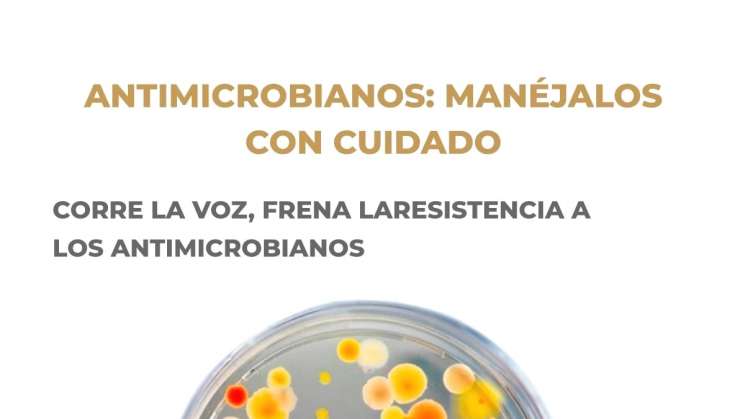
Promueve SSO uso responsable de medicamentos Antimicrobianos

Oaxaca.- A nivel mundial la resistencia a los medicamentos antimicrobianos principalmente antibióticos, causan anualmente alrededor de 700 mil muertes, lo que constituye para la Organización Panamericana de la Salud (OPS) una de las 10 amenazas principales a la salud pública, informaron los Servicios de Salud de Oaxaca (SSO).
Al respecto, el Responsable Estatal de Mortalidad Infantil, Enfermedad Diarreica e Infección Respiratoria Aguda en Menores de cinco años de la institución, Carlos Alberto Martínez Meingüer, sostuvo que los antimicrobianos – antibióticos, antivíricos, antifúngicos y antiparasitarios– son fármacos que se utilizan para prevenir y tratar infecciones en los seres humanos, animales y las plantas.
Sin embargo, el uso inadecuado de estas medicinas puede ocasionar un mayor riesgo de reacciones adversas, debido a que contribuye al desarrollo de resistencia, además, abusar de estos fármacos está amenazando su eficacia.
En el marco de la Semana Mundial de Concientización sobre el uso de Antimicrobianos-del 18 al 24 noviembre-el funcionario explicó que esta problemática surge cuando las bacterias, virus, hongos, así como parásitos, presentan cambios y dejan de responder a las medicinas, lo que hace más difícil el tratamiento de las infecciones, aumentando el riesgo de propagación de enfermedades graves.
El profesional de la salud señaló que el 70% de los antibióticos que se adquieren y suministran tanto para la niñez y personas adultas es producto de la automedicación y comúnmente son empleados para el tratamiento de infecciones respiratorias agudas, lo que trae como consecuencia padecimientos difíciles de tratar y el aumento de la mortalidad.
En este sentido puntualizó que el objetivo principal de esta semana conmemorativa que lleva por lema “Corre la voz, frena la resistencia a los antimicrobianos", es difundir el uso responsable de los fármacos, fomentar una cultura de la no automedicación y proveer mejores prácticas para evitar la expansión de la resistencia a los antibióticos entre la población en general, así como las y los profesionales de la salud.
Refirió que la recomendación para el personal médico es recetar adecuadamente los antibióticos de acuerdo a la enfermedad y edad del paciente, suministrar la cantidad de dosis conveniente, así como los periodos de la ingesta de los medicamentos.
En tanto, para quienes tienen algún síntoma de malestar físico deben acudir a valoración médica oportuna para disminuir el riesgo de complicaciones y terminar el tratamiento con todos los antibióticos recetados de la manera y por el tiempo que se haya indicado, así como evitar la automedicación.
Además, hizo énfasis al mencionar que los antimicrobianos deben evitarse para el tratamiento de Infecciones Respiratorias Agudas (IRAS), ya que más del 80% de las enfermedades son causadas por virus, y por ende no requieren medicación a base de antibióticos.

Esta conversación es moderada acorde a las reglas de la comunidad “Ciudadanía Express” . Por favor lee las reglas antes de unirte a ella.
Para revisar las reglas da clic aquí